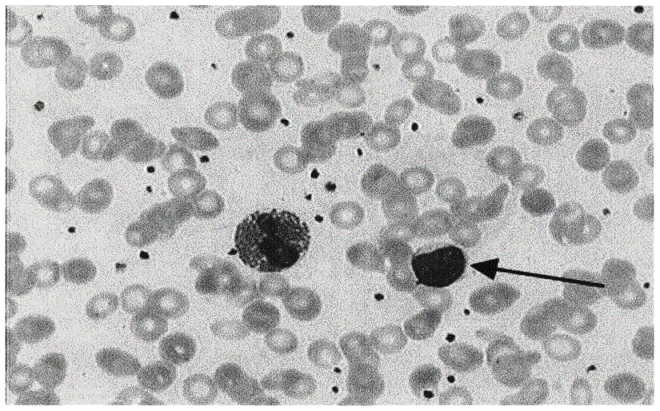

试题详情
- 简答题请报告箭头所指细胞的名称
关注下方微信公众号,搜题查看答案

热门试题
- 患者,女,44岁,突发右侧肢体乏力6小时
- 选择正确诊断( )
- 患者女,56岁,反复关节疼痛10年,活动
- 下列心电图检查最可能的是( )
- 请选出正确诊断( )
- 患者女性,38岁,突发左侧胸痛半小时。
- 下列心电图检查最可能的是( )
- 请选出正确诊断( )
- 下列心电图诊断最的是可能的是( )
- 男性,45岁,右大腿外伤1小时来诊,查X
- 患者男性,腹痛并皮肤黄染一周,行核磁共振
- 中年女性,42岁,因腹胀半年,加重伴进食
- 男,27岁,活动后突然右侧胸疼( )
- 患者男,40岁,腹痛1小时。
- 患者男,60岁,反复咳痰、咯血半年余。
- 女性,32岁,月经紊乱伴溢乳1年,头颅M
- 患者男性,61岁,既往高血压病史,突发昏
- 请选出正确诊断( )
- 患者男性,64岁,身高170cm,体重7
- 患者男,68岁,反复胸闷气促12年,加重